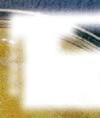

VL 2004 KFT.
Tisztelt Partnereink!
2023. július 1-jét követően a települési (lakossági) és egyéb olyan fémhulladékok, amelyek a koncesszió hatálya alá tartoznak, a MOL tulajdona, melyet vállalkozásunk nem tud átvenni.
MOL tulajdona:
• csomagolási hulladék (alumínium italos doboz)



• akkumulátor

• háztartási kis- és nagy gépek

• háztartási hulladék
• karosszéria hulladék és gépjárműalkatrész (villanymotor, hűtő, tárcsa) M1 személygépkocsi és N1 (tehergépkocsi 3,5 t össztömegig)


KONCESSZIÓ ALÁ NEM TARTOZÓ hulladékok melyet továbbra is átveszünk az alábbiak:
• építési, bontási, akár kisebb felújítási tevékenységből származó fémhulladék, idetartozhatnak: A természetes személy ingatlanán képződött építési és bontási fémhulladékok, mint például villamos szerelési munkálatokból, csőszerelésből, szerkezetépítésből, épületgépészeti munkák-

VL 2004 Kft
ból, kerti munkákból, egyéb otthoni építési, javítási, felújítási, barkácsolási munkálatokból keletkező fémhulladékok, megjelenésüket tekintve pl. csövek, pro lok, rudak, rácsok, különféle zártszelvények, betonacélok, lemezek, hengerelt acélok, kovácsoltvas elemek, ereszek, bádogok, gerendák, kábelek, huzalok, saválló, réz, alu konyhai és fürdőszobai szerelvények, csapok, mosogatók, ólom vízcsövek, radiátorok, kádak, tartályok, kerítésfonat, kapuelemek, hullámlemezek, lépcsők, csúszásgátló lemezek, távtartók fémhulladéka
• mezőgazdaságból származó fémhulladék akkumulátor és gumi nélkül,
• termelési, gyártási hulladék,







• minden egyéb (nem M1 és N1) gépjármű és motoros meghajtású közlekedési eszköz, pl. teherautó, munkagép, erőgép, vízi, légi jármű, mezőgazdasági jármű, pótkocsi, tömegközlekedési eszköz fémhulladéka egészben vagy feldarabolva. Akkumulátor és gumi nélkül.
Bővebb információért látogasson el weboldalunkra: vl2004.hu Minden Partnerünktől türelmet és megértést kérünk, senkinek sem könnyű a jelenlegi helyzet.

VL 2004 Kft.
Árváltozás jogát fenntartjuk. Árainkról a telepen érdeklődjön.
SZEGED, DOROZSMAI ÚT 33. (Bejárat a Penny Markettel szemben.) Telefon:
SZEGED–MAKÓ KÖRZETI 2023.
WEBÁRUHÁZ Minden egy helyen 1317780 1300997 Vas ...................................... 50 Ft/kg Lemez ................................ 40 Ft/kg Rézkábel ....................... 500 Ft/kg Alumínium, tiszta ..... 210 Ft/kg Horgany ........................ 250 Ft/kg Ólom ............................... 250 Ft/kg Saválló ........................... 250 Ft/kg Sárgaréz..................... 1300 Ft/kg Vörösréz, tiszta....... 2000 Ft/kg
augusztus 7., XXXII/32.
06-20/275-5141
•
• Szo.:
Nyitva: h–p.: 7.00–16.00
7.00–12.00
Tisztelettel:
Vas, színesfém felvásárlása: 1332742 2016. szeptember 8-tól szeptember 21-ig érvényes! 2023. augusztus 31-ig érvényes! 52% Profilkínálatunk középtömítéses 6 kamrás, 82 mm-es profillal bővült! Keresse bemutatótermünket: 6724 Szeged, Pulcz u. 33. Tel.: 06-30/577-8750 Tel.: 06-62/654-007 E-mail: szeged@huntherm.hu Nyitva: H-P: 8-16-ig HUN Th m ConsultingKft. 2016. szeptember 8-tól szeptember 21-ig érvényes! Díjtalan felmérés és szaktanácsadás. Ajtók és ablakok egyedi elképzelések szerint is! VÁSÁROLJA MEG MINŐSÉGI NYÍLÁSZÁRÓIT MAGYAR GYÁRTÓTÓL! www.huntherm.hu 1333323 1320906 Ácsmunkákat, tetőfedést, bádogozást vállalunk ingyenes felméréssel. Miklós Lajos www.outletfa.hu • Tel: +36 30 457 7047 1319837 ZÁRSZERELÉS Poprádi Bt. Poprádi Péter 06-30/292-3734, 06-62/267-871 1091733
Reluxa 30% kedvezményaugusztus 31-ig! 62/555-796, 30/9457-201 1318065
Redőny
EGÉSZSÉG,
ÁLLÁS–OKTATÁS
Algyői ruhaválogató cég (Texval Kft.)
Ügyfélszolgálat:
Párizsi krt. 27.
Telefon: 62/542-282
Nyitva: H–Cs.: 8–16-ig
Segédmunkást
keresünk villanyszerelő mellé
Főbb feladatok, munkák:
• Lakatos és/ vagy hegesztői munkálatok elvégzése
• Villamos alapszerelés kiépítésében való közreműködés,
• Tálcázásban és nyomvonalépítésben való segédkezés,
• Kisebb földmunkálatok elvégzése
Az álláshoz tartozó elvárások:
• Önálló munkavégzés,
• Csapatmunkára való hajlandóság,
• Megbízhatóság, gyors, pontos munkavégzés,

• Elkötelezett és lelkiismeretes hozzáállás
Amit kínálunk:
• Hosszútávú, stabil munkahely,
• Versenyképes fizetés és béren kívüli juttatások,
• Továbbtanulási lehetőségek.
Állás, munka területe(i):
• Szakmunka
• Villanyszerelő
• Teljes munkaidő
Szükséges tapasztalat:
• Hegesztő/lakatos végzettség előnyt jelent.
• Szükséges nyelvtudás:
• Nem igényel nyelvtudást
Munkavégzés helye: Csongrád-Csanád megye, ALGYŐ
Cég: Főnix Electric Kft

Elérhetőség: +36 30 453 5017, info@fonixelectric.hu
A RAMPF FORMEN Kft. gyártókapacitás fejlesztéséhez az alábbi munkakörre várja nagy gyakorlattal rendelkező, önállóan dolgozni tudó munkavállalók jelentkezését:
CNC Marógépkezelő: 3 műszak
Amit kínálunk:
törvény szerinti 30%-os műszakpótlék szombati rendkívüli munkavégzési
lehetőség, törvény szerinti 100%-os pótlék bónusz, jutalom teljesítménytől függően
munkába járási költségtérítés
SZÉP Kártya juttatás
hosszú távú, stabil munkahely szakirányú képzés, betanulás
Munkavégzés helye: Szeged
Jelentkezni lehet önéletrajzzal: munkaugy@rampf.hu vagy levelezési címen: 6791 Szeged, Széksósi út 58-60.
ANYAGVÁLOGATÓI, KÉZI ANYAGMOZGATÓI munkakörre FELVÉTELT HIRDET
férfiak és nők számára. Előny: kitartás, munkabírás! Érd.: 06-62-267-187.
E-mail: hr.texval@gmail.com
C-Mobil Kft szegedi telephelyére munkatársat keres
Feladatok:
• a telephely gyomtalanítása, zöldhulladék összegyűjtése
• az autószalonok külső környezetének tisztán tartása
• szemétgyűjtő konténerek környezetének rendben tartása
• általános telephelyrend biztosítása

Jelentkezését az alábbi elérhetőségeken várjuk. Cím: 6725 Szeged, Kálvária sgt 83-85. e-mail: allas@cmobil.com
Érdeklődni
OTTHON, ÉPÍTÉSZET, LAKBEREN DEZÉS, SZOLGÁLTATÁS

ÉPÜLETFA és FŰRÉSZÁRU
AKCIÓ
145 000 Ft 139 000 Ft/m³
Görcsmentes
UNGERBAUER
CSALÁDI BORPINCE 12-fajta minõségi PALACKOS és FOLYÓBOR széles választékban kapható. Nyitva: h-p 9-15, szombat 9-11 óráig.
CSONGRÁD Bokros part +36-30-300-7733 www.ungerbauer.hu



OSBAKCIÓLAP
a készlet erejéig (2500×1250 mm-es) 8–22 mm vastagságban 4495 – 11 315 Ft-ig.
ÚJ AKCIÓ:
Bramac léc 249 Ft/m Tetőléc 199 Ft/m
NYEREMÉNYJÁTÉK!
Gyalulást vállalunk!
www.cseribau.hu
A nálunk vásárolt épületfa impregnálását (gomba és rovar elleni védelem, mártással) díjmentesen végezzük!
Kiszállítás: Csongrád-Csanád vármegye területén 9990 Ft Hmvhely területén 5000 Ft
EUTR: AB3444916 & 0630 402-8431
















4 2023. augusztus 7. • 0 FT KISZÁLLÁSI DÍJ • VIDÉKRE IS • NON-STOP • KAMERÁS VIZSGÁLAT • TISZTA MUNKA-GARANCIA 06-70/630-3806 EGYED ADRIÁN DUGULÁS ELHÁRÍTÁS 1092212 Kertek teljes körű gondozása! Kertrendezés, bozótirtás, fakitermelés emelőkosaras géppel, kerítések építése, bontása, melléképület bontása kézi erővel is, szűk helyekről is. Suti Park Bt. 06-20/973-3225 1091739
LEMEZEK LEMEZEK & 0630 665-0209, 0630 161-5488 Hódmezővásárhely, Makói országút 38. www.hodlemez.hu kereskedelem@mechanikabt.hu és 1319747 1321560 extra minőségben! AUGUSZTUSI
TRAPÉZ- CSEREPES-
Hódmezővásárhelyi Fatelep
1333750
1333885 1330500
IMPRESSZUM
1333023 RENDELJE MEG ONLINE, MEGJELENIK OFFLINE! szuperinfo.hirdessemeg.hu þ KORSZERŰ þ EGYSZERŰ þ GYORS AKÁR MOBILRÓL IS KÉNYELMESEN HIRDETHET! CSÁNYI VILL ÉS TRANS Kft. • ÉPÜLETEK VILLANYSZERELÉSE • VEZETÉKEK CSERÉJE • PANELLAKÁSOK ÉS KISEBB MUNKÁK VÁLLALÁSA IS VILLANYSZERELÉST VÁLLALOK! Csányi László Péter • Tel.: 06-70/558-1971 vill.szerelo45@gmail.com • www.facebook.com/csanyivill Csongrád - Csanád vármegyén belül, hétfőtől péntekig. 1334156 1334215
régi vagy roncsautó átvétel, teljes körű okmányirodai ügyintézéssel, szállítással, költségmentesen. Autómentés
VAS ÉS SZÍNESFÉM LAKOSSÁGI ÉS CÉGES FELVÁSÁRLÁSA
ERECO Zrt. a Délép Ipari Parkban: Szeged, Dorozsmai út 35. Tel.: +36 20 459 9923 • e-mail: ereco.szeged@ecore.com







Nyitva tartás: hétfőtől péntekig 7.00–15.30-ig. Szombat, vasárnap zárva!
Extra árakkal várjuk régi és új partnereinket!
Pl.: horgany: 400 Ft/kg, tiszta alu: 300 Ft/kg, vas: 45 Ft/kg, lemez: 25 Ft/kg, ólom: 380 Ft/kg, saválló: 200 Ft/kg, sárgaréz: 1420 Ft/kg, vegyes vörösréz: 2320 Ft/kg, nyúzott vörösréz: 2580 Ft/kg, rézkábel: 550 Ft/kg. Az akkumulátor, a háztartási gépek, eszközök, gépjármű karosszéria elemek átvétele MEGSZŰNT!







Rovar- és rágcsálóirtás, fertőtlenítés.
Cégünk vállalja, hogy háziállatkímélő vegyszerekkel végzi az irtást, a HACCP uniós előírásoknak megfelelően. Fedora-Extra Kft. Tel.: 06-30/630-1469, 06-62/548-535, 06-30/946-1187. fedorakft@gmail.com web: www.fedora.hu

Kéri árnyékolástechnika
Exkluzív árnyékolók, tokozott napellenző, sávroló, fa reluxa, motoros aluredőnyök.
62/486-636, 20/9707-350 bambuszka29@gmail.com www.kericsaba.segitek.hu
(30)9457-577
(62)533-999
Forráskút, Forráskút dűlő 15. Telefon: 06-70/520-3808





www.fordex99.hu







Zártszelvények, szerkezeti, vezeték és varrat nélküli csövek, lemezek, betonhálók, betonacélok, laposacélok, köracélok, szögacélok, gerendák, patentívek, vágókorongok és elektródák. Kazánok, füstcsövek, fólia rögzítő csipesz.

C45, BC3, 42CrMo4, automata... stb. magasabb minőségű anyagok raktárról, rendelésre rövid határidővel.
Vágás, darabolás 240 mm-ig (szögben is), házhoz szállítás rövid határidővel!

5 2023. augusztus 7. 0 6 2 0 3 6 3 0 7 6 0 w w w s z o n y e g m o s o h u Szeged, Makó E L H O Z Z U K , K I M O S S U K , V I S S Z A V I S S Z Ü K 1068133 Az árváltoztatás jogát fenntartjuk.
1333013 Duguláselhárítás OLCSÓN, GYORSAN, GARANCIÁVAL!
Szász, A KIDUGÍTÓ!
1091742
1091668
1091621
1091931
és nehézgép szállítás! AUTÓBONTÓ FORGALOMBÓL VALÓ KIVONÁS, Autofrance Kft., Szilva Utcai Bontó Kft. Szeged, Díszlet u. 3. 30/943-5745, 20/616-0399 (Hívjon bármikor) 1306577 Száraz tölgyfa eladó! Méteres szálban 33.000 Ft/m3 Kuglizva 35.000 Ft/m3 Konyhakészen 38.000 Ft/m3 Erdei m3 is kapható! Rugalmaskiszállítás! Keressen bizalommal! 1331347 EUTR AA 3032659 06-30/892 72 96 Akácfa is kapható. A HUNOR COOP ZRt. BÉRBE ADJA az ÁSOTTHALOM, Királyhalmi utca 43. sz. alatti 379 m2 alapterületű VENDÉGLŐ üzlethelyiségét. Érd.: 30/682-3326 (munkanapokon) E-mail: ingatlan@hunorcoop.hu 1092272 OTTHON, ÉPÍTÉSZET, LAKBEREN DEZÉS, SZOLGÁLTATÁS Vas- és színesfém felvásárlás! Török Metals Kft. Algyő, JURA Ipari park, a 47-es út mellett. Nyitva: h–p.: 8-17, szo.: 8-12. 06-70/222-5838 www.torokmetals.hu Vas: 50 Ft/kg, Vaslemez: 40 Ft/kg, Festett alu: 380 Ft/kg, Alu öntvény: 400 Ft/kg, Rézkábel: 500 Ft/kg, További árainkat megtekinthetik a honlapon és a facebookon (@torokmetals)! Az árváltozás jogát fenntartjuk! Ebédszünet: 12.00–12.20-ig! 1333265 www.szuperinfo.hu Szegedi Szuperinfó 1334220
VÍZVEZETÉK-SZERELÉS, csőtörések elhárítása ásással is, mosogató, mosdó, csapok, szifonok, WC tartályok cseréjét vállalom. Tel.:06-20/613-6194
*1333142*
EGÉSZSÉGÜGY
PEDIKŰRÖZÉST vállalok, Szegeden házhoz megyek (körtöltésen belül!).
Tel.:06-30/995-1922
EGYÉB
*906216*
AKÁC tűzifa feldolgozva 27.000 Ft/ m3-45.000 Ft/m3, kiszállítva. Tel.:0670/418-8106 (AA5997617)
*1332868*
TELJESEN száraz vastag tölgy-szelezék kályhakészre vágva és hasított kályhakész bükk tűzifa kedvező áron rendelhető! Ingyenes, gyors házhozszállítás!
Tel.:06-30/2877-935, tel.:06-20/6230713. EUTR: AA6633031
*1332963*
TÜZELŐANYAG nagykereskedés. Száraz, vastag tölgy-szelezék, tölgy-bükk konyhakészre aprítva, kalodázva (Tavalyi kitermelés!) kedvező áron rendelhető készlet erejéig! Gyors kiszállítás! Tűzrevaló-Trans Kft. Tel.:06-70/316-4431, tel.:06-20/462-9787 EUTR-AA5958063
*1332916*
TŰZIFA eladó! Tölgy, kőris, szilva 35.000 Ft/m3, nyárfa 25.000 Ft/m3 kiszállítva! Tel.:06-30/217-5575, tel.:06-70/5068000. EUTR: AA5987762
*1332890*
ELTARTÁS, GONDOZÁS
BEJÁRÓNŐ Marika néni vállal házimunkát, bevásárlást, orvoshoz kísérést, igény szerint eltartást. Autóval, jogosítvánnyal rendelkezem. Becsületes, leinformálható. Tel.:06-30/154-6317
*1333105*
ELTARTÁSI szerződést kötnék, de életjáradék fizetés is érdekelne! Tel.:+36-30/354-6236.
*1328778*
IDŐSKORI életjáradékot fizetnék lakásért, vagy házért, vagy eltartást nyújtanék takarítással, főzéssel, bevásárlással, orvoshoz menettel (szükség esetén 0-24 felügyelettel), ügyvédi okirattal. Autóval rendelkezem. Tel.:06-70/650-5550
*1325810*
VEGYES
FELVÁSÁRLÁS! Azonnali készpénzfizetéssel vásárolunk teljes hagyatékot (ruhaneműtől az edényekig mindent elszállítunk), valamint vásárolunk HI-FI tornyot, hangfalakat, erősítőt, légpuskát (nem engedélykötelest!)hűtőszekrényt, antik bútorokat, képeket, falitányérokat, porcelánokat, dísztárgyakat, faliórát, régi karórát, jelvényeket, kitüntetéseket, csillárt, könyveket, régi rádiót, szódásüvegeket, konyhai berendezési tárgyakat (tányér, edény, stb.) régi és modern játékokat (legókat, kisvasutat, társasjátékot, stb.)., műhelyfelszámolásból származó szerszámokat. Valamint lakáskiürítést, lomtalanítást vállalunk. Tel.:06-70/415-4013
*1083235*
ASZTALOKAT, régi bútorokat, képeket, faliórát porcelánt, komódot, padokat, régi nagyszekrényt, húsvágó asztalt, demizsont, ballont, 8-50 l-es üvegeket, teljes hagyatékot vásárolok. Tel.:06-30/3543210, Tel.:06-70/505-9040
*1333879*
AKCIÓS * TŰZIFA KAPHATÓ!
DUNNÁT, párnát, bútort, dísztárgyakat, használt tollat,porcelánt veszek.Hívásra házhoz megyek. Tel.:06-30/164-6336
*1332923*
DUNNÁT, párnát és tollat veszek magas áron. Tel.:06-30/354-3210, tel.:06-70/505-9040
*1333878*
HAGYATÉKOT, régi bútort keresek, veszek, takarítását vállalom. Tel.:06-30/858-2932
*1332852*
HORGÁSZCSÓNAK horganyzott lemez 340x100x60 cm jó állapotban eladó Hódmezővásárhelyen. Tel.:06-70/518-9777
*1333887*
IÏŐS hölgy, úr eltartását, gondozását vállalom.Gépjárművel rendelkezem. Teljeskörű segítséget biztosítok. Tel:06301487933



*1333975*
INDÍTÓ, nevelő, befejező és tojótáp rendelhető. Termékeinket ingyenesen kiszállítjuk Szeged és Szeged környéki településekre. Tel.:06-30/360-6662
*1333103*
KÖNYVET, régi pénzt veszek. Tel.:0630/354-3210, tel.:06-70/505-9040
*1333876*
KÖNYVHAGYATÉKOT, könyvtárat vásárolok készpénzért.
Tel.:06-30/276-7093
*1333095*
NAPRAFORGÓS roppantott tojó takarmánykeverék eladó. Tel.:06-30/705-1569
*1333116*
PÁLINKAFŐZŐK ÉS BORKÉSZÍTŐK!
Illatos, muskotályos és egyéb szőlőfajták előjegyezhetők zúzva-bogyózva. Irsai, Cserszegi, Bianca, Néró, Szürkebarát, Chardonnay, Zweigelt, Pinot Noir, Zöldveltelíni, Sauvignon, Kékfrankos, Rajnai rizling, Cabernet, Kadarka. Érd.:+36-30/300-7733.
E-mail: ungerbauer@ungerbauer.hu


*1333739*
REHAB elektromos moped eladó. Nem használt. Tel.:06-70/568-6196
*1333796*
RENDEZVÉNYEKRE hűtőkocsi bérelhető. Tel.:06-20/467-1180
*1323399*
SZEKRÉNYSOR, 2 db, lakkozott, jó állapotú, 15000 Ft/db, eladó. Tel.:06-20/952-4457
*1332473*
TRAPÉZLEMEZ, cserepelemez, többféle színben és méretben, hosszú garanciával eladó. Tel.:06-30/665-0209, tel.:06-30/161-5488. www.hodlemez.hu


*1333145*
HIRDETÉSÉT FELADHATJA BÁRHONNAN, BÁRHOVA!
APRÓHIRDETÉSI SZELVÉNY
1334224 1334227
LAKOSSÁGI APRÓHIRDETÉS FELADÁSÁHOZ
Minimum 10 szó, ára br.1778 Ft. 10 szó felett a hirdetés díja szavanként br.178 Ft.
Szuperinfó Magyarország Média Kiadói Kft. Szeged, Párizsi krt 27. • Telefon: 62/542-282
Hirdetés szövege: ...................................................................................................................................................................
Érdeklődni (cím, telefonszám):
Rovat megnevezése:
Megjelenés dátuma (hete):
A következőt kell tennie: Írja le hirdetését a fenti területre, vágja ki a kupont és hozza be személyesen a szerkesztőségbe: Szeged, Párizsi krt 27. Nyitva tartás: h–cs.: 8–16-ig. Lapzárta: szerda, 16 óra.
Minimum 10 szó, ára br.1778 Ft. 10 szó felett a hirdetés díja szavanként br.178 Ft. A kupon csak a Szeged-Makó Körzeti Szuperinfóban megjelenő hirdetéshez használható fel. Telefonos hirdetésfelvétel nincs, hirdetését CSAK SZEMÉLYESEN TUDJA FELADNI vagy online: www.szuperinfo.hu
Megrendelő neve, címe:
Köszönjük, hogy nálunk hirdet!
33.000 Ft/m3
Tölgy, cser, bükk, akác Szállítás kisebb-nagyobb mennyiségben! *Az akció 2023. 08. 15-ig érvényes! AA5926440 Tel.: 06-20/290-7870
7 2023. augusztus 7. 1332108
1331828
KÉRÜNK MINDEN FEHÉR MEZŐT KITÖLTENI!
Dátum: Áraink az áfát tartalmazzák!
A NAP 24 ÓRÁJÁBAN! www.szuperinfo.hu
0% THM















11999 Ft
16,99% THM 10 HÓNAPRA! 48 HÓNAPRA!

Minden LG, Sharp, Candy, Whirlpool, Gorenje, Indesit, Bosch és Liebherr hűtőszekrényre, fagyasztószekrényre, fagyasztóládára!

































169 999 Ft


























készpénzára: 1 875 000 Ft, önrész: 375 000 Ft) a havi törlesztôrészlet: 42 548 Ft, referencia THM: 16,99%, futamidô: 48 hónap, hitelkamat(fix): évi 16,99%, teljes visszafizetendô összeg: 2 042 304 Ft, a hitel teljes díja (kamat): 542 304 Ft (a hitel teljes díjában foglalt díj: 0 Ft; jutalék: 0 Ft; költség: 0 Ft; adó: 0 Ft).
THM: 0%. Futamidő: 10 hónap. Hitelösszeg: 40.000 Ft és 1.500.000 Ft között. Önerő: 40.000 Ft és 600.000 Ft között: 0%; 600.000 Ft felett: min. a vételár 20%-a. Érvényes 2023.08.03. és 2023.08.16. között Expert üzleteiben és a szórólapban megjelölt LG, SHARP, CANDY, WHIRLPOOL, GORENJE, INDESIT, BOSCH ÉS LIEBHERR hűtőszekrényre, fagyasztószekrényre, fagyasztóládára. Az X SYSTEM Zrt.




























































































csak háztartási mennyiséget szolgálunk ki. A szórólapban megjelent egyes termékek csak rendelésre kaphatóak, részletekről érdekődjön az üzletben. Szórólapos áraink 2023. augusztus 3-tól 2023. augusztus 16-ig, vagy a készlet erejéig érvényesek és forintban értendőek, az áfát tartalmazzák. A hirdetett TV készülékek alkalmasak a magyarországi földfelszíni, szabad hozzáférésű digitális televíziós műsorszórás vételére. A szórólapban megjelenő árak 1 db termék megvásárlása esetén érvényesek. A szórólapban szereplő képek csak illusztrációk, szín- és típuseltérés előfordulhat. A nyomdai hibákért felelősséget nem vállalunk!



8 2023. augusztus 7.
Szeged, Párizsi krt. 8-12. vigyen szakértelmet otthonába! EXPERTNET.HU THM: 16,99%. Futamidő: 10-48 hónap. Hitelösszeg: 50.000 Ft és 1.500.000 Ft között. Önerő: 50.000 Ft és 600.000 Ft között: 0%; 600.000 Ft felett: min. a vételár 20%-a. A 16,99% THM 48 hónap futamidő és legalább 100.000 Ft hitelösszeg esetén érvényes. Érvényes 2023.08.03. és 2023.08.16. között az újságban megjelölt termékekre. Az X SYSTEM Zrt. a Cofidis Magyarországi Fióktelepe hitelközvetítőjeként jár el. Reprezentatív példa Cofidis Áruhitel igénylése esetén: 1 500 000 Ft hitelösszeg esetén (termék/szolgáltatás
20/942-1642
a Cofidis Magyarországi Fióktelepe hitelközvetítőjeként jár el. Reprezentatív példa Cofidis Áruhitel igénylése esetén: 1 500 000 Ft hitelösszeg esetén (termék/szolgáltatás készpénzára: 1 875 000 Ft, önrész: 375 000 Ft) a havi törlesztôrészlet 150 000 Ft, referencia THM:
teljes visszafizetendô összeg: 1 500 000 Ft, a hitel teljes díja (kamat): 0 Ft (a hitel teljes díjában foglalt díj: 0 Ft; jutalék: 0 Ft; költség: 0 Ft; adó: 0 Ft). Üzleteinkben
0,00%, futamidô: 10 hónap, hitelkamat (fix): évi 0,00%,
ALULFAGYASZTÓS HŰTŐ LI7 SN2E W 1 • 295 liter • 197/98 literes hűtő/fagyasztó tér • No Frost, Pure WInd technológia • 3 állítható hűtőpolc • Ma: 176,3 cm x Sz: 59,5 cm x Mé: 65,5 cm, szín: fehér UHD SMART LED TV UE43AU7022 • 108 cm (43”), Ultra HD 4K (3840 x 2160) • DVB-T2/S2/C • Tizen operációs rendszer • Netflix, YouTube, HBO MAX • Bluetooth, 3 HDMI, 1 USB 124 999 Ft Törlesztőrészlet: 48× 3 545 Ft THM: 16,99% Áruhitel Önerő: 0 Ft 108cm G Törlesztőrészlet: 10× 16 999 Ft THM: 0% Áruhitel Önerő: 0 Ft ELEKTROMOS TŰZHELY E3241AW • 68 literes, PerfectGrill • HomeMade formatervezés • SilverMatte könnyen tisztítható zománc • dupla üvegajtó hőelvezető réteggel bevonva A 99 999 Ft Törlesztőrészlet: 48× 3 403 Ft THM: 16,99% Áruhitel Önerő: 0 Ft FELÜLTÖLTŐS MOSÓGÉP BTW L50300 EU/N • 5 kg, 1000 fordulat/perc • Turn&Wash • Water Balance+ • késleltetett indítás funkció 119 999 Ft D POWERBANK ADATA AP20000QCD-DGT-CBK AP20000QCD-DGT-CWH • 20000 mAh kapacitás • LCD kijelző • USB-C csatlakozás 89 999 Ft PARTYBOX MX-ST50B/EN • akár 18 óra üzemidő • Bluetooth • USB • IPX5 fröccsenésálló 16 999 Ft BLUETOOTH FEJHALLGATÓ JBL T510BT BLACK • beépített mikrofon • akár 40 óra üzemidő F ALULFAGYASZTÓS HŰTŐ MDRB380FGF01 • 270 liter • 199/71 literes hűtő/fagyasztó tér • gyorsfagyasztás, Megfordítható ajtónyitás • 4 polc, 3 ajtórekesz • hőmérséklet-szabályozás • Ma: 180 cm x Sz: 54,5 cm x Mé: 62,25 cm, Szín: fehér 144 999 Ft Törlesztőrészlet: 48× 4 113 Ft THM: 16,99% Áruhitel Önerő: 0 Ft NO FROST F FAGYASZTÓSZEKRÉNY HM3509 • 242 liter kapacitás,7 fiók • mechanikus hőfokszabályozó • megfordítható ajtó, Ma: 170 cm x Sz: 60 cm x Mé: 60 cm, szín fehér 169 999 Ft Törlesztőrészlet: 48× 4 822 Ft THM: 16,99% Áruhitel Önerő: 0 Ft KOMBINÁLT TŰZHELY GK5C62WH • 70 literes • GentleClose lassú ajtózáródás • MultiAir • 1 részlegesen kihúzható teleszkópos sínpár • Dupla üvegajtó hőelvezető réteggel 129 999
A Törlesztőrészlet: 48× 3 687 Ft THM: 16,99% Áruhitel Önerő: 0 Ft Törlesztőrészlet: 48× 3 971 Ft THM: 16,99% Áruhitel Önerő: 0 Ft
Ft
E MOSOGATÓGÉP QW-NA1CF47EI-EU • 13 terítékes • 4 program • 3 hőmérsékletfokozat • Eco Clean • féltöltet opció • gyermekzár 20 999 Ft PRESSZÓ KÁVÉFÔZÔ SZV624 • 2 és 6 személyes kávészűrővel • skálázott üveg kiöntő edénnyel • biztonsági szelepes zárócsavarral ELEKTROMOS BOROTVA S1133/41 • PowerCut pengék • 4D Flex borotvafejek • akár 40 perc működési idő • ergonomikus kialakítás 13 999 Ft UHD SMART LED TV 55UQ75003LF • 139 cm (55”) képátló • Ultra HD 4K (3840×2160) felbontás • DVB-T2/S2/C • webOS operációs rendszer • Netflix, YouTube, HBO MAX • Bluetooth • 3 HDMI, 1 USB 159 999 Ft 139cm G Törlesztőrészlet: 48× 4 538 Ft THM: 16,99% Áruhitel Önerő: 0 Ft E 1332013
139 999 Ft